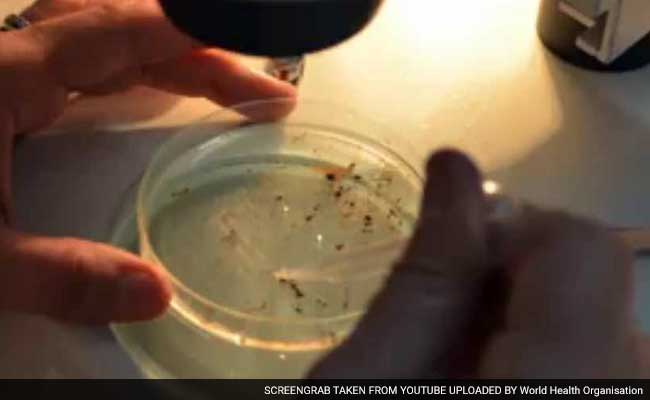
जीका वायरस : खिलाड़ियों में भी समाया डर, रियो ओलिंपिक पर मंडराया खतरा

Aedes
-
{
- सब
- ख़बरें
- वीडियो
-

National Dengue Day 2025: डेंगू के मच्छरों से इस तरह बचाएं परिवार को, ये नुस्खे घर में नहीं आने देंगे एक भी Mosquito
- Friday May 16, 2025
- Written by: सीमा ठाकुर
National Dengue Day Theme: डेंगू का बुखार जानलेवा साबित हो सकता है. ऐसे में डेंगू से बचे रहना बेहद जरूरी होता है. आज राष्ट्रीय डेंगू दिवस के मौके पर जानिए किस तरह डेंगू से बचकर रह जा सकता है.
-
 ndtv.in
ndtv.in
-

डेंगू और मलेरिया में क्या अंतर होता है? कौन-सा मच्छर फैलाता है डेंगू और मलेरिया? जानिए इलाज, लक्षण और बचाव के तरीके
- Friday April 25, 2025
- Written by: अवधेश पैन्यूली
World Malaria Day: डेंगू और मलेरिया दोनों ही अलग-अलग बीमारियां हैं. इनके लक्षण और कारणों में काफी अंतर है. यहां जानिए कौन सी चीजें इन्हें एक दूसरे से अलग करती हैं.
-
 ndtv.in
ndtv.in
-

World Mosquito Day: डेंगू के बढ़ रहे हैं मामले, जानिए Dengue के मच्छरों से बचे रहने के लिए क्या करें
- Sunday August 20, 2023
- Written by: सीमा ठाकुर
World Mosquito Day 2023: डेंगु मच्छरों से होने वाली एक जानलेवा बीमारी है जिससे बचे रहने के लिए कुछ बातों का ध्यान रखना जरूरी है.
-
 ndtv.in
ndtv.in
-

कुछ लोगों को दूसरों से ज़्यादा मच्छर क्यों काटते हैं? वैज्ञानिकों ने दिया यह जवाब
- Thursday October 20, 2022
- Edited by: वर्तिका
64 वॉलेंटियर्स (Volunteers) को अपने हाथों पर नायलॉन की स्टॉकिंग पहनने को कहा गया ताकि उनकी त्वचा की गंध ली जा सके. इन स्टॉकिंग (Stocking) को एक अलग ट्रैप में रखा गया जो एक लंबी ट्यूब से जुड़ा था. फिर इसमें दर्जनों मच्छर (Mosquito) छोड़े गए.
-
 ndtv.in
ndtv.in
-

Keep Away Aedes Mosquitoes : डेंगू फैलाने वाले एडीज मच्छरों को दूर रखने के ये हैं खास उपाय
- Thursday October 14, 2021
- Edited by: अनु चौहान
अक्सर मच्छर रात के वक्त काटते हैं लेकिन डेंगू फैलाने वाले एडीज मच्छरों की प्रवृत्ति थोड़ी अलग होती है, ये दिन की रोशनी में काटते हैं. इन जानलेवा मच्छरों से खुद को और अपने परिवार को बचाना है तो कुछ खास बातों का ध्यान देना बेहद जरूरी है.
-
 ndtv.in
ndtv.in
-

जिन लोगों के खून में है इस चीज़ की कमी, वो ज्यादा हो रहे हैं Dengue के शिकार
- Tuesday September 17, 2019
- Reported by: IANS, Edited by: रेणु चौहान
जिन लोगों के खून में लौह तत्व (Iron) की कमी होती है उनसे मच्छरों के जरिए दूसरे लोगों को डेंगू (Dengue) के संक्रमण का खतरा अधिक होता है. एक अध्ययन में यह दावा करते हुए विशेषज्ञों ने बताया कि बीमारी के दौरान लौह तत्वों का सेवन करने वाले रोगी मच्छरों के काटने से होने वाले इस रोग के प्रसार को बढ़ने से रोक सकते हैं.
-
 ndtv.in
ndtv.in
-

जीका वायरस : खिलाड़ियों में भी समाया डर, रियो ओलिंपिक पर मंडराया खतरा
- Saturday January 30, 2016
- Edited by: Bhasha
जीका वायरस का खतरा अमेरिकी महाद्वीप के साथ ही दुनियाभर में मंडरा रहा है। ब्राजील भी इनमें से एक है, जहां छह महीने बाद ओलिंपिक का आयोजन होना है। अब सबसे बड़ा सवाल यह है कि क्या ब्राजील समय रहते जीका वायरस पर लगाम लगा सकेगा...
-
 ndtv.in
ndtv.in
-

National Dengue Day 2025: डेंगू के मच्छरों से इस तरह बचाएं परिवार को, ये नुस्खे घर में नहीं आने देंगे एक भी Mosquito
- Friday May 16, 2025
- Written by: सीमा ठाकुर
National Dengue Day Theme: डेंगू का बुखार जानलेवा साबित हो सकता है. ऐसे में डेंगू से बचे रहना बेहद जरूरी होता है. आज राष्ट्रीय डेंगू दिवस के मौके पर जानिए किस तरह डेंगू से बचकर रह जा सकता है.
-
 ndtv.in
ndtv.in
-

डेंगू और मलेरिया में क्या अंतर होता है? कौन-सा मच्छर फैलाता है डेंगू और मलेरिया? जानिए इलाज, लक्षण और बचाव के तरीके
- Friday April 25, 2025
- Written by: अवधेश पैन्यूली
World Malaria Day: डेंगू और मलेरिया दोनों ही अलग-अलग बीमारियां हैं. इनके लक्षण और कारणों में काफी अंतर है. यहां जानिए कौन सी चीजें इन्हें एक दूसरे से अलग करती हैं.
-
 ndtv.in
ndtv.in
-

World Mosquito Day: डेंगू के बढ़ रहे हैं मामले, जानिए Dengue के मच्छरों से बचे रहने के लिए क्या करें
- Sunday August 20, 2023
- Written by: सीमा ठाकुर
World Mosquito Day 2023: डेंगु मच्छरों से होने वाली एक जानलेवा बीमारी है जिससे बचे रहने के लिए कुछ बातों का ध्यान रखना जरूरी है.
-
 ndtv.in
ndtv.in
-

कुछ लोगों को दूसरों से ज़्यादा मच्छर क्यों काटते हैं? वैज्ञानिकों ने दिया यह जवाब
- Thursday October 20, 2022
- Edited by: वर्तिका
64 वॉलेंटियर्स (Volunteers) को अपने हाथों पर नायलॉन की स्टॉकिंग पहनने को कहा गया ताकि उनकी त्वचा की गंध ली जा सके. इन स्टॉकिंग (Stocking) को एक अलग ट्रैप में रखा गया जो एक लंबी ट्यूब से जुड़ा था. फिर इसमें दर्जनों मच्छर (Mosquito) छोड़े गए.
-
 ndtv.in
ndtv.in
-

Keep Away Aedes Mosquitoes : डेंगू फैलाने वाले एडीज मच्छरों को दूर रखने के ये हैं खास उपाय
- Thursday October 14, 2021
- Edited by: अनु चौहान
अक्सर मच्छर रात के वक्त काटते हैं लेकिन डेंगू फैलाने वाले एडीज मच्छरों की प्रवृत्ति थोड़ी अलग होती है, ये दिन की रोशनी में काटते हैं. इन जानलेवा मच्छरों से खुद को और अपने परिवार को बचाना है तो कुछ खास बातों का ध्यान देना बेहद जरूरी है.
-
 ndtv.in
ndtv.in
-

जिन लोगों के खून में है इस चीज़ की कमी, वो ज्यादा हो रहे हैं Dengue के शिकार
- Tuesday September 17, 2019
- Reported by: IANS, Edited by: रेणु चौहान
जिन लोगों के खून में लौह तत्व (Iron) की कमी होती है उनसे मच्छरों के जरिए दूसरे लोगों को डेंगू (Dengue) के संक्रमण का खतरा अधिक होता है. एक अध्ययन में यह दावा करते हुए विशेषज्ञों ने बताया कि बीमारी के दौरान लौह तत्वों का सेवन करने वाले रोगी मच्छरों के काटने से होने वाले इस रोग के प्रसार को बढ़ने से रोक सकते हैं.
-
 ndtv.in
ndtv.in
-

जीका वायरस : खिलाड़ियों में भी समाया डर, रियो ओलिंपिक पर मंडराया खतरा
- Saturday January 30, 2016
- Edited by: Bhasha
जीका वायरस का खतरा अमेरिकी महाद्वीप के साथ ही दुनियाभर में मंडरा रहा है। ब्राजील भी इनमें से एक है, जहां छह महीने बाद ओलिंपिक का आयोजन होना है। अब सबसे बड़ा सवाल यह है कि क्या ब्राजील समय रहते जीका वायरस पर लगाम लगा सकेगा...
-
 ndtv.in
ndtv.in